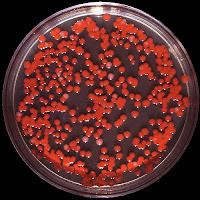

Read this article! and have another way of looking at the wonders, in light of the bloody microbiologia.Panes in a church, crisis of faith, do miracles?. Ignorance and supersticion.Ciencia ....
Source: Paper presented by the IES Fco de Orellana de Trujillo (Caceres), the DON BOSCO NATIONAL AWARD
0 comments:
Post a Comment